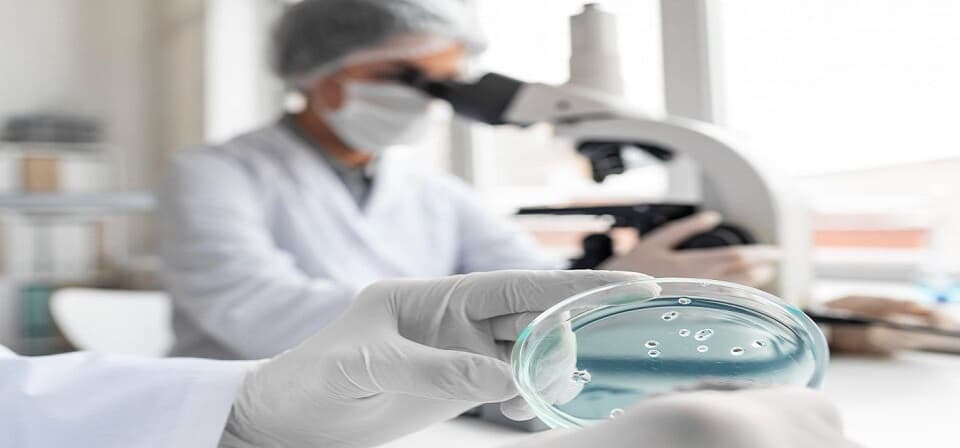

What You Need to Know to Get Started Your Career in Clinical Embryology
Clinical embryology is a fascinating and vital field within healthcare that focuses on the development and manipulation of human embryos. This article explores the ins and outs of clinical embryology, the importance of this field, career opportunities, educational requirements, and the skills needed to succeed.
What is Clinical Embryology?
Clinical embryology is a branch of medical science that specializes in the study and management of human embryos. It plays a pivotal role in assisted reproductive technologies (ART), including in vitro fertilization (IVF), gamete cryopreservation, and preimplantation genetic diagnosis. Clinical embryologists work closely with reproductive endocrinologists and embryologists to ensure the successful creation and implantation of embryos.
Why is Clinical Embryology Important?
- Fertility Solutions: It offers hope to couples struggling with infertility by facilitating procedures like IVF and intracytoplasmic sperm injection (ICSI).
- Genetic Screening: Clinical embryologists can screen embryos for genetic disorders, helping prevent the inheritance of serious conditions.
- Research Advancements: The field contributes to scientific discoveries and medical breakthroughs, advancing our understanding of early human development.
- Ethical Considerations: Clinical embryologists help navigate complex ethical dilemmas surrounding embryo research and assisted reproductive technologies.
Career Opportunities in Clinical Embryology
As a clinical embryologist, you can explore diverse career options, including:
- Embryology Laboratory Technician: Handling and maintaining laboratory equipment and conducting basic procedures.
- Clinical Embryologist: Specializing in IVF and ART procedures, ensuring the successful development of embryos.
- Research Scientist: Contributing to scientific studies in reproductive medicine, genetics, and embryology.
- Genetic Counsellor: Advising patients on genetic risks and choices related to their embryos.

Learn everything you need to know to start your career in clinical embryology, including education and training requirements, job market outlook, skills and qualities needed, and tips for success.
Qualifications and Training
To become a clinical embryologist, you'll need:
- A Bachelor's degree in biology, biochemistry, or a related field.
- A Master's degree in clinical embryology or a related discipline.
- Hands-on training in an embryology laboratory.
- Certification from recognized organizations like the American College of Embryology.
Skills and Personal Qualities
Success in clinical embryology requires a mix of technical skills and personal qualities:
- Attention to Detail: Precision is paramount when handling delicate embryos and genetic material.
- Problem-Solving: Be prepared to tackle unexpected challenges during complex procedures.
- Empathy: Supporting patients emotionally through their journey is crucial.
- Ethical Judgment: Navigate complex ethical issues with sensitivity and professionalism.
Education and Training
Consider enrolling in specialized clinical embryology programs offered by reputable institutions. Pursuing a graduate degree in clinical embryology like a PG diploma in clinical embryology and M.Sc in clinical embryology, etc., offers numerous benefits, including in-depth knowledge, hands-on experience, and networking opportunities.
Experience
Prior experience is valuable in clinical embryology training, as it demonstrates your competence and dedication. You can gain experience through:
- Internships at fertility clinics or research laboratories.
- Volunteering for community health organizations.
- Collaborating on research projects with experienced clinical embryologists.
Job Search
When searching for clinical embryology jobs, explore:
- Fertility Clinics and Hospitals
- Research Institutions
- Government Health Agencies
- Academic Institutions
Online job portals and professional networks like LinkedIn are excellent resources for job listings.
Crafting a Strong Resume and Cover Letter
When applying for clinical embryology positions, create a compelling resume and cover letter:
- Highlight relevant coursework, certifications, and hands-on training.
- Showcase your passion for embryology and commitment to patient care.
- Tailor your application to the specific job description.
The Job Interview
Prepare for clinical embryology job interviews by:
- Reviewing your academic and practical experience.
- Anticipating questions about ethical challenges and patient interaction.
- Demonstrating your commitment to continuing education in the field.
Conclusion
Clinical embryology is a dynamic and rewarding field that plays a crucial role in helping individuals achieve their dreams of parenthood. With dedication, the right education, and a genuine passion for the field, you can embark on a fulfilling career in clinical embryology. SEART encourages you to take the first step toward becoming a clinical embryologist and making a positive impact on the world of reproductive medicine. Your journey begins here.